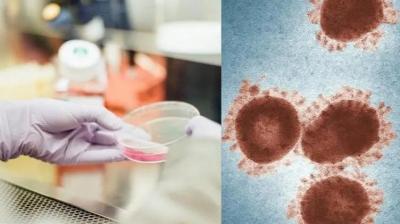

Coronavirus XE Variant: भारतात XE व्हेरिएंटमुळे येणार कोरोनाची चौथी लाट? 'या' लक्षणांकडे दुर्लक्ष करू नका
By ऑनलाइन लोकमत | Updated: April 11, 2022 20:19 IST2022-04-11T20:16:10+5:302022-04-11T20:19:26+5:30

कोरोनाचा नवीन व्हेरिएंट XE ने भारतातील २ राज्यांमध्ये शिरकाव केला आहे. बीएमसीने दावा केला आहे की, मुंबईत पुन्हा XE व्हेरिएंट संक्रमित रुग्ण आढळला आहे, तर गुजरातमध्येही एका व्यक्तीचा अहवाल नवीन व्हेरिएंटचा पॉझिटिव्ह आला आहे.

प्राथमिक अहवालानुसार, कोविड-19 चा हा नवीन व्हेरिएंट ओमायक्रॉननंतर(Omicron) अत्यंत संक्रामक आहे आणि खूप वेगाने पसरतो. महाराष्ट्र आणि गुजरातमध्ये XE व्हेरिएंटचे 2 नवीन रुग्ण आढळल्यानंतर, लोकांना चौथ्या लाटेची चिंता वाटू लागली आहे.

XE हा Omicron च्या २ सब व्हेरिएंट BA.1 आणि BA.2 चा एक रिकॉम्बिनंट स्ट्रेन आहे आणि जागतिक आरोग्य संघटनेने हा व्हेरिएंट कोरोनाच्या BA.2 व्हेरिएंटपेक्षा १० टक्के जास्त संसर्गजन्य असल्याचं सांगितले आहे. मात्र XE व्हेरिएंट हलका असल्याचं दिसतं असं तज्ज्ञ सांगतात.

तत्पूर्वी कोणत्याही विषाणूपासून दूर राहण्यासाठी त्याची लक्षणे जाणून घेणे अत्यंत आवश्यक आहे. म्हणून, या बातमीत XE व्हेरिएंटचे लक्षणं तसेच XE व्हेरिएंट भारतात चौथी लहर आणू शकेल का? हे सावधगिरीने जाणून घेणार आहोत
हिंदुजा हॉस्पिटल अँड मेडिकल रिसर्च सेंटर, खार येथील सल्लागार डॉ. भरेश देधिया यांच्या मते, XE हायब्रीड स्ट्रेनच्या प्रकारात वैद्यकीयदृष्ट्या फरक करता येत नाही. नवीन सब-व्हेरियंट XE सर्व लक्षणांमध्ये Omicron सारखेच असल्याचे दिसते. हे सहसा सौम्य असते आणि फारसे गंभीर नसते.

हे लक्षात घेतले पाहिजे की XE व्हेरियंटला जवळपास ३ महिने झाले आहेत आणि अद्याप Omicron प्रमाणे जगभरात पसरलेले नाहीत. त्यामुळे असे म्हणता येईल की हा वेगळा प्रकार नसून तो ओमायक्रॉनसारखाच आहे असं डॉक्टरांनी सांगितले.

आत्तापर्यंत, XE प्रकाराची लक्षणे विद्यमान व्हेरिएंटपेक्षा वेगळी असल्याचा कोणताही पुरावा नाही. तज्ञांनी आतापर्यंत नमूद केलेल्या XE व्हेरिएंटची लक्षणं अशी आहेत: थकवा, सुस्ती, ताप, डोकेदुखी, शरीर दुखणे, घाबरणे, हृदयासंबंधित समस्या

WHO चे मुख्य शास्त्रज्ञ सौम्या स्वामीनाथन यांच्या मते, XE व्हेरिएंट डेल्टा व्हेरिएंटइतका धोकादायक असणार नाही. भारतातील बहुतांश लोकांचे लसीकरण करण्यात आले आहे. सुरुवातीच्या माहितीनुसार, हा व्हेरिएंट इतर व्हेरिएंटपेक्षा १० टक्के वेगाने पसरतो.

परंतु सध्या या व्हेरिएंटवर अधिक अभ्यास केला जात आहे. आतापर्यंत, संक्रमित रुग्णांची गंभीर प्रकरणे नोंदवली गेली नाहीत. रोटरी क्लब ऑफ मद्रासच्या कोविड टास्क फोर्सचे संचालक डॉ. पवित्रा वेंकटगोपालन यांनी चौथ्या लाटेबद्दल सांगितले

XE व्हेरिएंटमुळे नवीन लाट येईल हे आम्ही सांगू शकत नाही. या साथीच्या आजारादरम्यान अनेक व्हेरिएंट ओळखले गेले आहेत, त्यापैकी बहुतेक अत्यंत संसर्गजन्य नव्हते आणि बर्यापैकी संपले. २०२२ पासून यूकेमध्ये या व्हेरिएंटची चर्चा होत आहेत, परंतु आतापर्यंत कमी गंभीर रुग्ण आढळली आहेत. या व्हेरिएंटसाठी पुरेशी अँन्टीबॉडी लोकांमध्ये आहेत. त्यामुळे पुढील लाटेची शक्यता फारच कमी आहे असं ते म्हणाले.

















